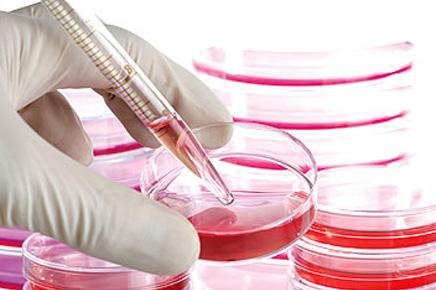

دراسة تكشف عن نتائج واعدة لعلاج إصابات النخاع الشوكي بالخلايا الجذعية
المدينة نيوز - قالت شركة أسترياس بيوثيرابيتكس إن البيانات الأولية لدراسة صغيرة أظهرت أن علاج الخلايا الجذعية الرائد يمكن أن يحسن الحركة لدى مرضى أصيبوا بالشلل نتيجة إصابة في النخاع الشوكي.
وعقار "أو.بي.سي-1" هو أول منتج مستخلص من أجنة بشرية يدخل مرحلة التجارب على البشر.
ونجاح العقار ضروري لإثبات أن أبحاث الخلايا الجذعية للأجنة يمكن أن تعالج أمراضاً مثل السرطان والشلل الرعاش، وحالات صحية خطيرة مثل نقص المناعة والجلطات وإصابات النخاع الشوكي.
وأظهرت البيانات أن شدة الإصابة في النخاع الشوكي تراجعت لدى المريض الأول، كما تمكن مريضان آخران من استئناف برامج التأهيل فور حقنهما بالخلايا الجذعية.
واختبرت دراسة سابقة مزايا جرعة صغيرة من مليوني خلية جذعية أعدت لتتطور داخل الجهاز العصبي.
واشترت أسترياس عقار "أو.بي.سي-1" عام 2013 من شركة جيرون التي كانت في ذلك الوقت رائدة أبحاث الخلايا الجذعية، ثم قررت التركيز على تطوير عقاقير لعلاج السرطان.
واختارت جيرون التخلي عن علاج الخلايا الجذعية عام 2011 بعد أن اصطدم البحث بجدل حول الإجهاض، ما دفع عدداً من شركات التكنولوجيا الحيوية إلى التزام الصمت بشأن أبحاثها.










